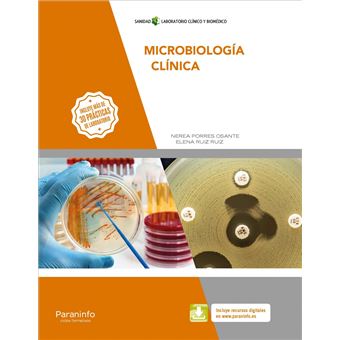
Microbiología Clínica - 1

Microbiología Clínica
Elena Porres Osante Nerea Ruiz Ruiz
Estado :
Novo
Vendido por
País de expedição : Espanha
Comentários do vendedor
Microbiología clínica
Resumo
Este libro está dirigido a los alumnos del ciclo formativo de gradosuperior que conduce a la obtención del título de técnico superior enlaboratorio clínico y biomédico, perteneciente a la familiaprofesional de sanidad. la obra consta de nueve unida
Outras ofertas

Microbiología Clínica
Resumo
Este libro está dirigido a los alumnos del ciclo formativo de gradosuperior que conduce a la obtención del título de técnico superior enlaboratorio clínico y biomédico, perteneciente a la familiaprofesional de sanidad. la obra consta de nueve unida
Publicidade
Avaliações dos nossos clientes
Microbiología Clínica
Sê o primeiro a dar
a tua opinião sobre este produto
Características
- Editora
-
Paraninfo
- Idiomas
-
Espanhol
- EAN
-
9788428340267
Publicidade
Publicidade